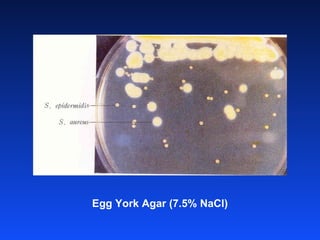
Egg York Agar (7.5% NaCl)

I stafilococchi gram-positivi, in particolare Staphylococcus aureus, sono patogeni comuni con capacità di causare infezioni attraverso la produzione di tossine e l'invasione dei tessuti. Questi batteri possono essere trasmessi attraverso contatti interpersonali e alimenti contaminati, rappresentando un rischio significativo per la salute. La loro resistenza agli antibiotici, evolutasi rapidamente, ha reso difficile il trattamento e dilagano frequentemente in ambienti ospedalieri.